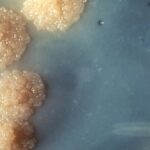
Tuberculose Vaccin

Cette douleur que vous connaissez bien frappe vraiment plus vite que celle de l’accouchement
De récentes expériences ont montré que la douleur provoquée par ’arrachage d’un cheveu voyageait jusqu’au cerveau beaucoup plus rapidement que les autres.

De récentes expériences ont montré que la douleur provoquée par ’arrachage d’un cheveu voyageait jusqu’au cerveau beaucoup plus rapidement que les autres.

Une équipe de l’université de Nagoya a développé un « jeu d’arcade » unique en son genre, en utilisant une approche qui pourrait trouver des applications dans le domaine de la nanomédecine.

L’étude de plus de 200 000 glaciers révèle une perte de glace totale de plusieurs milliers de milliards de tonnes depuis 2000, s’étant considérablement accélérée au cours de la dernière décennie.

Grâce à des caméras télécommandées en Norvège, nous avons la chance de découvrir le premier aperçu détaillé des oursons polaires sortant de leurs tanières, dans des vidéos réalisées il y a plus de 10 ans.

Le sommeil est capital pour notre bien-être. Ce que l’on fait en journée a aussi un impact sur la qualité de notre sommeil.

Soucieux de votre bien-être, le Daily Geek Show vous propose aujourd’hui un produit qui pourrait très rapidement devenir votre nouveau meilleur ami… En effet, ce fauteuil de relaxation très confortable va vous changer la vie.

ENGWE continue d’innover en proposant des vélos électriques au rapport qualité/prix impressionnant. Avec le MAPFOUR N1 AIR, la marque frappe fort en misant sur un cadre en fibre de carbone, une conception ultra-légère et une assistance électrique performante. Ce vélo electrique est conçu pour les cyclistes urbains exigeants qui recherchent à la fois confort, puissance et maniabilité.

La chaleur, quand elle est extrême, peu nous épuiser et jouer négativement sur notre humeur. Selon une nouvelle étude américaine qui s’intéresse à la question urgente de savoir comment la chaleur extrême affecte les humains, elle peut également accélérer le vieillissement.

Ayant recouvert la ville antique de Pompéi et ses voisines de plusieurs mètres de matériau volcanique, l’éruption du Vésuve en 79 de notre ère a également vitrifié le cerveau d’un malheureux. De récentes recherches ont permis de faire la lumière sur ce cas unique.
James Cameron sera le premier réalisateur à indiquer au début de Avatar 3 que son film n’a pas été réalisé à partir d’une IA.

L’astuce est désormais disponible dans le cadre du dernier noyau de Linux, la version 6.13.

Le trou noir au cœur de notre galaxie est un véritable fêtard qui souffle sans cesse des bulles cosmiques.

Récemment, une équipe de chercheurs a réussi à créer un appareil qui s’attache au tuyau d’échappement de n’importe quelle voiture et qui est capable de transformer les gaz d’échappement en électricité.

Aujourd’hui, nous vous proposons de découvrir cette photographie Google Maps prise en 2021. Elle révèle une une mystérieuse tache sombre triangulaire au milieu de l’océan Pacifique. Alors que cette dernière a suscité d’étranges rumeurs concernant son origine, il s’avère qu’il s’agit d’une petite île avec une couverture forestière incroyablement dense.

Récemment, Meta a publié une nouvelle publicité pour Horizon Worlds, son application de réalité virtuelle. Toutefois, le résultat est particulièrement horrible.

Dans l’ensemble, les scientifiques ont déterminé que les animaux contribuent collectivement à hauteur d’au moins 76 000 gigajoules d’énergie par an pour façonner la surface de la Terre.

Récemment, des archéologues allemands et grecs ont trouvé la plus ancienne preuve connue de pollution au plomb due à l’activité humaine. Et cela date d’il y a plus de 5 000 ans.
Le nouveau vaccin à base de nanoparticules lipidiques et d’ARNm a démontré une forte réponse immunitaire et une protection renforcée contre le MCB.

Soucieux de votre bien-être, le Daily Geek Show vous propose aujourd’hui un produit qui pourrait très rapidement devenir votre nouveau meilleur ami… En effet, le masseur Alljoy a pour objectif de soulager n’importe quelle douleur musculaire, qui touchent chaque année des millions de Français… Présentation.

D’après les résultats de l’étude publiée dans la revue Scientific Reports, il n’y a aucune différence entre le passé et le futur et le temps peut ainsi s’écouler vers l’avant ou vers l’arrière en raison de processus se déroulant au niveau quantique.